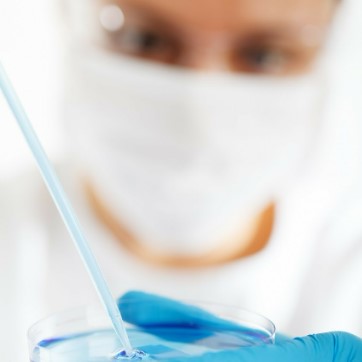

y tú te preguntaras ... ¿Qué es este sitio?
Yo te lo cuento
Pues ya que estas aquí… te explico. Quiero abrir tu mente, quiero que sientas una explosión en tu cerebro. Quiero explicarte los avances en BIOTECNOLOGÍA, que van a producir una Revolución Genética.
REVGEN
No se que se estudia en la carrera de Biotecnología, yo te voy a explicar mi concepto de BIOTECNOLOGÍA. Es decir:
«Todos la avances Tecnológicos que puede afectar a la VIDA, en concreto a la vida de los seres humanos, de ti y de mi.»
Trabajas, te emparejas, te reproduces, te jubilas y mueres…. y así es…. pero así NO será.
Si sigues el guión que te propongo, descubrirás cómo los científicos están avanzado de una manera BRUTAL en un camino solo transitado en nuestras cabezas por esos seres imaginarios llamados DIOSES.:

- Se está avanzando en vivir más , incluso en vivir para siempre.
- Se está avanzado en revertir el envejecimiento, es decir en rejuvenecer.
- Se está avanzado en cambiar lo que somos, en editar nuestro ADN y cambiar nuestro ser, eliminar nuestros errores genéticos e incluso adquirir nuevas características.
- Se está avanzando en conectar nuestro cerebro a máquinas, a redes, a otros humanos.
- Se está avanzando en agregar a nuestro cuerpo nuevos periféricos / órganos / aparatos / apéndices bionics que nos complementen.
BLOG - REVGEN
Noticias sobre la Revolución Genética que se esta produciendo.
Todos los que encuentre ... estén donde estén, los unifico ordeno por temáticas y te los comparto, para que solo te dediques a asimilar la información.
Que leer y ver

Todo esto no solo está en las explicaciones de los científicos, está en series, está en películas y está en libros.
En esta sección te ire agregando todo aquello que puedes leer o ver y que te recomiendo. Son series de tele, son libros, son pelis… una manera distinta de ir aprendiendo y entendiendo mas… sobre todo en esta sección vas a ver consecuencias, ficticias por supuesto… pero quién sabe si algún día serán ciertas!
Son las principales fuentes de información que yo utilizo para enterarme de que es lo que está sucediendo.
Son un montón de fuentes, y la información es muchísima, así que no me da tiempo de procesarlo todo ni aunque fuera un transhumano de 1000 años, así que si hay algo que te interesa, te puedes inscribir a esas fuentes de información y luego contárnoslo a los demás.